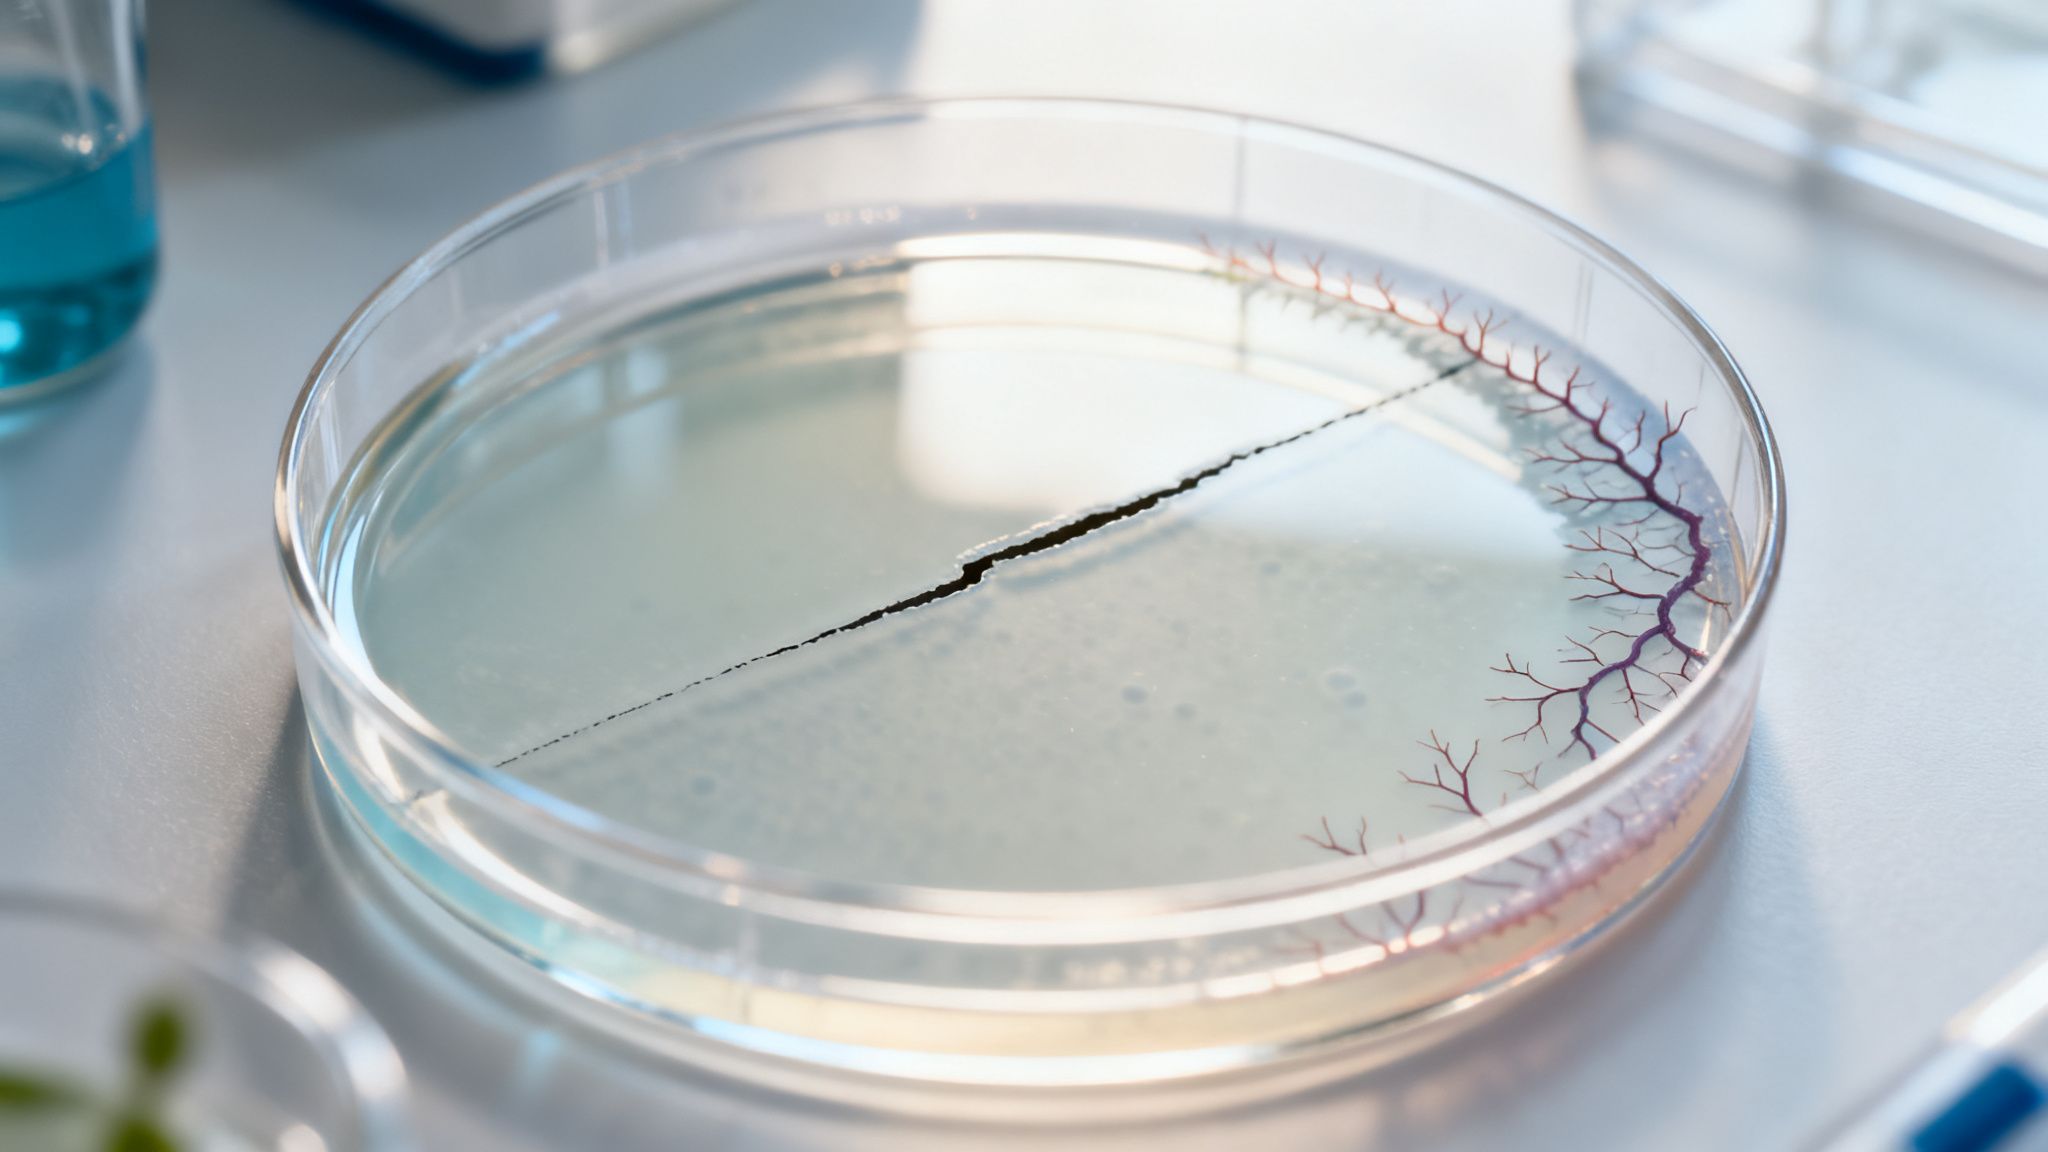
A petri dish in a lab with a black crack and distinct reddish-purple tree-like growth pattern.

Imagine your body has its own elite special forces unit—a single soldier that’s a master of offense, defense, and battlefield medicine all at once. That soldier is the LL-37 peptide.
This guide is a deep dive into the science behind the remarkable LL-37 peptide, exploring how this naturally occurring molecule wages war on pathogens, accelerates tissue repair, and intelligently commands the immune system. We'll unpack the science with clear analogies and real-world studies, giving you a solid, research-grade understanding of its potential.
The Power of Your Body's Elite Defender
LL-37 isn't just another molecule; it's a cornerstone of our innate immune system, the very first line of defense against invasion. You'll find it in specialized immune cells called neutrophils and standing guard on the surfaces of your skin and mucosal linings, ready to act at a moment's notice.
Its sheer versatility is what makes it such a compelling subject for researchers across so many different fields.
A Molecule of Many Talents
The primary benefits of LL-37 observed in the lab really boil down to three core functions. Each one of these is a major field of study for scientists trying to crack the code of the body's natural defense and repair systems.
- Antimicrobial Action: It's a direct-action weapon, attacking and neutralizing a huge range of pathogens, including bacteria, viruses, and fungi.
- Wound Healing and Tissue Repair: It actively encourages the growth of new blood vessels and signals skin cells to move to injury sites, which has been shown to speed up recovery in experimental models.
- Immune Modulation: Think of it as a sophisticated thermostat for the immune system. It can ramp up the response to fight an infection or dial it down to prevent dangerous, runaway inflammation.
This peptide's ability to wear multiple hats—as an antimicrobial agent, a healing promoter, and an immune regulator—is what makes it so fascinating. It doesn’t just perform one job; it coordinates a complex, multi-pronged response to cellular threats and damage.
Before we dive deeper, here's a quick summary of the key research areas where LL-37 truly shines.
LL-37 Peptide Key Research Benefits At a Glance
This table summarizes the primary areas of in vitro research where LL-37 shows significant promise, providing a quick overview for researchers.
| Area of Research | Observed In Vitro/Preclinical Benefit | Relevance to Researchers |
|---|---|---|
| Antimicrobial Studies | Directly kills a broad spectrum of bacteria (including antibiotic-resistant strains), fungi, and viruses. Disrupts biofilms. | A potential model for developing new antimicrobial agents and understanding how the body naturally combats infection and biofilms. |
| Wound Healing | Promotes keratinocyte migration, angiogenesis (new blood vessel formation), and re-epithelialization in cell culture and animal models. | Offers insights into the cellular mechanisms of tissue repair, with applications in dermatology and regenerative medicine research. |
| Immunomodulation | Can either amplify or suppress immune responses by influencing cytokine production and immune cell recruitment. | Crucial for studying the balance between effective pathogen clearance and harmful inflammation in autoimmune or inflammatory conditions. |
| Anti-Cancer Research | Exhibits selective cytotoxic effects on certain cancer cell lines while sparing normal cells in some in vitro studies. | Provides a potential avenue for exploring novel, targeted anti-cancer therapies that leverage innate immune mechanisms. |
This at-a-glance view highlights just how versatile LL-37 is, making it a valuable tool across diverse fields of biological and medical research.
Why This Matters for Research
For any investigator, the real appeal of LL-37 is its multifaceted nature. Some compounds are one-trick ponies, but LL-37 gives us a window into deeply interconnected biological processes.
A researcher studying antibiotic resistance, for example, might be laser-focused on its unique ability to disrupt bacterial biofilms. At the same time, a scientist in regenerative medicine could be examining its power to accelerate wound closure in cell cultures.
While LL-37 is a key player in innate immunity, researchers exploring other areas, like the best peptides for muscle growth, often find overlapping mechanisms in cellular repair and signaling pathways. Getting a firm grip on these core functions is the foundation for designing sharp, targeted experiments and interpreting your results with confidence.
How LL-37's Molecular Blueprint Works
To really get a handle on the wide-ranging benefits of LL-37, we need to look at its brilliant molecular design. Think of it less like a chemical and more like a highly specialized tool engineered by nature—a double-sided key that unlocks our immune defenses while locking down microbial threats. This isn't magic; it's a masterclass in biophysics.
The story of LL-37 starts with a larger precursor protein called hCAP18. When cleaved, it yields the active LL-37 peptide, which is defined by two critical traits. First, it's cationic, meaning it carries a net positive electrical charge. Second, it's amphipathic, a fancy way of saying one end of the molecule loves water (hydrophilic) while the other is drawn to fats and oils (hydrophobic). This dual personality is the secret to its incredible versatility.
The Magnetic Pull Towards Microbes
That positive charge is the peptide's built-in targeting system. You see, the surfaces of most bacteria and fungi are packed with negatively charged molecules. Just like opposite ends of a magnet snapping together, LL-37 is irresistibly drawn to these microbial membranes, while mostly ignoring the neutrally charged membranes of our own human cells.
This selective attraction ensures it focuses its firepower right where it's needed: on the invaders. Once it makes contact, its amphipathic nature takes over. The fat-loving, hydrophobic part of the peptide literally worms its way into the fatty lipid bilayer of the microbial membrane, causing chaos and destabilizing the whole structure.
This mechanism isn't like a subtle poison; it's a brute-force physical assault. LL-37 punches holes and rips open gaps in the microbe's protective outer wall. This causes all its vital internal contents to leak out, leading to a very quick death. Because it's a physical attack, it's also incredibly difficult for bacteria to evolve resistance against it.
This diagram shows how these structural features translate directly into LL-37's three main roles in research settings.

As you can see, the peptide acts as a central hub for defending against pathogens, repairing tissue, and commanding the broader immune response.
A Battlefield Commander for the Immune System
But LL-37 is far more than just a frontline killer. Its molecular design also allows it to act as a crucial signaling molecule—a true battlefield commander for the immune system. It doesn't just fight the enemy; it calls in and directs reinforcements.
This process is known as chemotaxis, where LL-37 essentially acts as a chemical beacon. It binds to specific receptors on our immune cells—like neutrophils, monocytes, and T-cells—and guides them straight to the site of an infection or injury. This creates a rapid, coordinated response right at ground zero.
The real genius, though, is in the nuance of its signaling. Depending on the context and the specific threat, LL-37 can orchestrate completely different outcomes:
- Rallying the Troops: During an acute infection, it can trigger the release of pro-inflammatory signals, calling more immune cells to join the fight and amplifying the defensive response.
- Keeping the Peace: On the flip side, it can also promote anti-inflammatory signals. This is critical for preventing the immune response from spiraling out of control and causing friendly-fire damage to healthy tissue.
- Calling in the Medics: It also signals to cells involved in regeneration, like keratinocytes and fibroblasts, telling them it's time to start rebuilding and healing the damaged area.
This remarkable ability to fine-tune the immune response is a cornerstone of LL-37's power. Its structure allows it to dock with a whole host of cellular receptors, making it a master regulator that can dial the immune system's activity up or down as needed. It’s not just a soldier; it's the entire command-and-control center, ensuring the body's response is powerful, precise, and perfectly balanced.
A Potent Weapon Against Microbial Threats

While researchers are exploring a whole host of benefits associated with LL-37, its raw power as an antimicrobial agent is what often steals the show. This isn't just some passive defense mechanism. Think of LL-37 as an aggressive, front-line weapon in our innate immune system, capable of neutralizing a stunningly wide range of invaders—bacteria, viruses, and fungi—in laboratory settings.
It’s not just the breadth of its activity that’s impressive, but its potency. LL-37 has proven effective against some of the most stubborn pathogens known to science, making it a hot topic for anyone looking into the future of antimicrobial strategies.
Dismantling Bacterial Fortresses
One of the biggest headaches in microbial research is the biofilm. Picture a fortress built by bacteria—a slimy, intricate shield they create to hide from antibiotics and immune cells. This protective layer makes them incredibly difficult to eradicate.
This is where LL-37 shines. It acts like a biological siege weapon, breaking down the walls of these bacterial strongholds. Research has shown that even at low concentrations, LL-37 disrupts the integrity of biofilms, exposing the vulnerable bacteria within. It's this unique talent that has put LL-37 on the map for so many scientists.
The ability of LL-37 to break down biofilms is critical. It suggests a mechanism that doesn't just kill free-floating microbes but also addresses the root of persistent, hard-to-treat infections by destroying their defensive structures.
Because of this, LL-37 is a key compound in studies aiming to find new ways to tackle chronic infections that depend on biofilm formation to survive.
A Killer Instinct Against S. aureus
To get a real sense of its power, let’s look at how it performs against Staphylococcus aureus. This is the notorious bug behind everything from skin infections to severe pneumonia. It’s particularly common in places like gyms, where shared equipment creates a perfect breeding ground for tough strains like MRSA.
Back in 2012, a pivotal study demonstrated just how lethal LL-37 is to a clinical strain of S. aureus. At a concentration of just 250 nM, the peptide achieved a 100% kill rate in a mere 30 minutes. This wasn't even a close fight; it dramatically outperformed the control agents used in the experiment. You can explore the full results to see how these findings are shaping antimicrobial research.
This rapid, complete destruction of a clinically relevant pathogen in a lab setting really highlights one of LL-37's most compelling benefits: its sheer efficiency.
More Than Just Antibacterial
As impressive as its bacterial takedowns are, LL-37’s defensive resume doesn't stop there. Researchers have documented its activity against a variety of other microbial threats, cementing its role as a versatile defender.
- Antiviral Properties: In vitro studies show LL-37 can interfere with the life cycle of several viruses, either by blocking them from entering host cells or by gumming up their replication machinery.
- Antifungal Action: The peptide also packs a punch against various fungi. Much like with bacteria, it tears into the fungal cell membrane, causing cell death.
This broad-spectrum capability is what makes LL-37 such a fascinating molecule. It isn't a specialized tool for one type of threat; it's more like a master key that can handle a diverse array of microbial challenges. Better yet, because it physically disrupts microbial membranes rather than targeting a specific metabolic pathway, it's much harder for pathogens to develop resistance. For research applications, that intrinsic quality is perhaps one of its most valuable features.
Accelerating Tissue Repair And Recovery
While LL-37's ability to take on microbial threats is impressive, its role as a master of reconstruction is arguably even more compelling. This peptide doesn't just clear away invaders; it actively directs the complex, delicate process of rebuilding damaged tissue.
Think of it as the construction foreman at the site of an injury. When a wound occurs, LL-37 shows up not just to neutralize bacteria but to start issuing directives. It signals other cells to get to work, coordinating a swift and efficient repair from the ground up. This makes it a fascinating subject for anyone in regenerative science.
Driving Cellular Action for Healing
LL-37’s regenerative power isn’t just a concept; it’s backed by its direct influence on the cellular machinery essential for wound closure. In the lab, two of its most significant actions are promoting angiogenesis and stimulating cell migration.
- Angiogenesis: This is the formation of new blood vessels. LL-37 coaxes endothelial cells—the cells lining blood vessels—to grow and form new networks. This is absolutely critical for getting oxygen and nutrients to the healing wound.
- Cell Migration: The peptide also acts as a powerful chemoattractant, basically waving a flag that tells skin cells like keratinocytes and fibroblasts to move into the damaged area. This movement is the very first step in closing the gap and rebuilding the skin's protective barrier.
By quarterbacking these two fundamental processes, LL-37 effectively lays the foundation for complete tissue restoration in experimental models.
Clinical Insights from a Landmark Study
The real excitement about LL-37's healing potential kicked into high gear when it moved from the lab into a groundbreaking first-in-man trial. Researchers tested its effects on venous leg ulcers (VLUs)—chronic, notoriously stubborn wounds that plague millions of people. This study gave us some of the first hard evidence of the peptide's regenerative power in a real-world setting.
In the Phase I/II study, patients received topical LL-37 at different concentrations, and the results were stunning. The group receiving a 0.5 mg/mL dose saw their wound areas shrink by an average of 68%. Even more telling, their healing rate constant was a full sixfold higher than the placebo group, showing a dramatic acceleration in repair. And all of this was achieved with an excellent safety profile. You can dive into the specifics by reading the full research about these wound healing findings.
This trial was a pivotal moment. It took the cellular mechanisms we saw in petri dishes and translated them into tangible, measurable healing in one of the toughest clinical scenarios. It really solidified LL-37’s reputation as a potent agent for tissue repair.
A Tool for Regenerative Research
For scientists, these findings highlight exactly why LL-37 is such a valuable tool for studying recovery and regeneration. It gives us a model for understanding how the body's own defense systems are beautifully, intricately linked to its repair mechanisms.
The peptide doesn't just fight; it actively participates in the healing that comes after. This dual-action capability is where so much exciting research is happening now.
Whether you're studying the basic science of wound closure or exploring new compounds, LL-37 is a prime example of how one molecule can coordinate a multifaceted biological response. Understanding these pathways is key, much like with other peptides that influence cellular activity. For a different perspective on cellular signaling, you can learn more about the Glow Peptide in our article. Ultimately, LL-37 stands out as an essential compound for any researcher investigating the powerful intersection of immunity and tissue regeneration.
Conducting The Body's Immune Response
One of the most fascinating things about LL-37 is its role as a master conductor of the immune system. It doesn't just play one note; it directs the entire orchestra, making sure the response is powerful when needed and dialed back when the threat is gone. This function, known as immunomodulation, is what really sets LL-37 apart as a remarkably intelligent molecule.
Think of it like a sophisticated thermostat for your immune system. When an infection pops up, LL-37 cranks up the heat, calling in immune cells to attack. But just as crucially, it knows when to cool things down, preventing the system from boiling over into a state of chronic inflammation that can do serious damage to healthy tissues.
This dual capability is absolutely essential for maintaining immune homeostasis—that perfect state of balance. Without this careful regulation, the body could either fail to put up an effective fight or, worse, turn on itself and trigger autoimmune conditions.
A Two-Sided Coin: Pro-Inflammatory And Anti-Inflammatory Actions
The real genius of LL-37 is how it behaves based on the situation. It’s not locked into one mode of action. Instead, it adapts its strategy based on the specific signals it gets from its environment, allowing it to play two roles that seem contradictory but are actually perfectly complementary.
- Amplifying Defenses: When facing an immediate threat, like a bacterial invasion, LL-37 acts as a potent pro-inflammatory agent. It recruits key immune cells like neutrophils and macrophages straight to the scene, ensuring a swift and powerful defense is launched to take out the invaders.
- Calming the Storm: On the flip side, once the threat is neutralized, LL-37 can completely switch gears. It helps suppress the inflammatory response, putting a stop to the prolonged inflammation that's at the heart of many chronic diseases and helping the body get back to normal.
This knack for regulation makes LL-37 a prime candidate for researchers who are digging into conditions marked by immune dysregulation, from tough-to-treat infections to autoimmune disorders.
Insights from Clinical Investigations
The real-world implications of this immunomodulatory power have been put to the test in various clinical settings. A 2014 clinical trial, for example, looked at what happened when LL-37 was injected directly into melanoma tumors. While the study's main goal was to check for safety, it was built on the peptide's known talent for recruiting immune cells—a core strategy in modern cancer immunotherapy. This same chemotactic skill is why LL-37 is also being studied for its antiviral and biofilm-busting properties. You can learn more about these trial findings and what they mean for immune research.
More evidence of its modulating role comes from studies on inflammatory conditions like periodontitis. In one trial with 30 patients, successful treatment resulted in a drop in local LL-37 levels. This suggests the peptide's presence was directly tied to the active inflammation, and its decrease was a clear signal that immune balance was being restored.
This ability to both sound the alarm and signal the "all-clear" is central to LL-37's value in research. It provides a model for understanding how the body achieves a controlled, effective, and ultimately self-limiting immune response.
At the end of the day, LL-37 acts as a biological blueprint for balanced immunity. Its capacity to fine-tune the body's defenses—ramping them up to fight infection and then calming them down to promote healing—is a core part of its function. For scientists, this peptide offers a unique tool to probe the intricate dance between aggression and resolution that defines a healthy immune system.
Essential Lab Protocols For Handling LL-37
To get the most out of LL-37 in any study, your results have to be both valid and reproducible. That journey begins the moment the peptide arrives in your lab. Proper storage, reconstitution, and handling aren't just tedious steps—they are the very foundation of good science, ensuring the peptide keeps its structural integrity and biological punch.
Think of research-grade LL-37 like a finely tuned instrument. If you treat it carelessly, you’ll dull its effectiveness and skew your data. The first thing to know is that you'll be working with it in two different states: as a lyophilized (dry) powder and as a reconstituted (liquid) solution.
Storage Best Practices For Stability
How long LL-37 remains stable is entirely dependent on its state. When you receive it, the peptide will be in its much more durable lyophilized form, which is ideal for long-term storage.
- Lyophilized State: For maximum shelf life, keep the dry powder tucked away at -20°C or colder. In these frozen conditions, it will stay stable for months, sometimes even years, ready for future experiments.
- Reconstituted State: The moment you add a solvent, the clock starts ticking. The liquid solution is far more fragile and should be stored at 4°C and used within a few days to avoid degradation.
A rookie mistake is to reconstitute your entire batch of LL-37 at once if you don't plan to use it right away. The gold standard is to prepare smaller, single-use aliquots from your stock solution. These can be frozen at -20°C, extending their utility and, crucially, avoiding the repeated freeze-thaw cycles that will tear the peptide's structure apart.
To make this easier, here’s a quick-reference guide for keeping your LL-37 in prime condition. Following these simple protocols is key to ensuring the peptide remains stable and your experimental results are reliable.
LL-37 Handling and Storage Protocol
| State | Recommended Storage Temperature | Duration | Key Considerations |
|---|---|---|---|
| Lyophilized (Powder) | -20°C or colder | Months to years | This is the most stable form for long-term storage. |
| Reconstituted (Stock) | 4°C (refrigerated) | A few days | Use quickly to prevent degradation. Avoid multiple freeze-thaw cycles. |
| Reconstituted (Aliquots) | -20°C or colder | Several weeks | Best practice for preserving peptide integrity over multiple experiments. |
Sticking to these guidelines helps protect your investment and, more importantly, the validity of your data.
Reconstitution For Specific Assays
Picking the right solvent and nailing the concentration is make-or-break for your experimental design. The goal is simple: get the peptide fully dissolved without damaging its function. While sterile, deionized water is often the go-to solvent, you should always double-check the Certificate of Analysis provided by your supplier for specific advice.
Your experimental goal will dictate how you prepare it. For instance, testing its bug-killing power requires a different setup than seeing how it makes cells move.
- Minimum Inhibitory Concentration (MIC) Assays: To find out how well LL-37 stops bacterial growth, you would reconstitute the peptide and then create a series of dilutions in a liquid culture medium. The aim is to pinpoint the lowest concentration that prevents any visible microbial colonies from forming.
- Wound Healing or Cell Migration Assays: If you want to see how LL-37 encourages cells to move, you’d add the reconstituted peptide to your cell culture medium at a precise, non-toxic concentration to see its effect on cells like keratinocytes or fibroblasts.
Getting this step right is absolutely fundamental. For a more detailed walkthrough, check out our guide on how to reconstitute peptides, which offers a step-by-step process that works for many research compounds.
The Research Use Only Disclaimer
Finally, we have to talk about the legal and ethical boundaries. Every research-grade peptide, LL-37 included, is sold strictly for Research Use Only (RUO). This isn't just fine print; it's a critical designation.
It means these compounds are meant for laboratory experiments and in vitro studies—and that's it. They are not drugs, they are not for human or animal use, and they have not been approved by the FDA for any kind of therapeutic, diagnostic, or clinical application. Respecting this RUO status is a non-negotiable pillar of responsible scientific work.
Answering Your Top Questions About LL-37
When you start digging into the research on LL-37, a few common questions always seem to pop up. Let's tackle them head-on, so you can build your experiments on a rock-solid understanding of how this peptide really works in vitro.
How Is LL-37 Different From a Standard Antibiotic?
The key difference is how it attacks microbes. Think of it as physical warfare versus chemical warfare.
LL-37 is a physical disruptor. Its positive charge is irresistibly drawn to the negatively charged surface of a microbe's membrane. Once it latches on, it literally punches holes in the membrane, causing the cell to leak its contents and die almost instantly.
Traditional antibiotics, on the other hand, are much more subtle. They typically work by interfering with a specific internal process, like building cell walls or replicating DNA. Because LL-37's assault is purely physical, it’s incredibly difficult for bacteria to evolve a defense against it. This unique mechanism is a huge reason why it’s getting so much attention in the research community.
How Can LL-37 Be Both Pro- and Anti-Inflammatory?
It seems contradictory, but this dual-action capability is what makes LL-37 such a sophisticated immune modulator. Its behavior is all about context—it's like a field commander who knows exactly when to charge and when to call for a ceasefire.
- During an Infection: When your cells sense danger, LL-37 acts as a rally cry. It becomes pro-inflammatory, calling in immune cells to the site of invasion to neutralize the threat.
- During Healing: Once the immediate danger is over, it completely flips its script. It promotes anti-inflammatory signals to calm the chaos, prevent friendly fire from damaging healthy tissue, and kickstart the repair process.
This incredible ability to dial the immune response up or down as needed is what sets LL-37 apart. It’s not a simple on/off switch; it’s a dynamic regulator that works to restore balance, or homeostasis.
Why Does Peptide Purity Matter So Much in Experiments?
This one is non-negotiable. Using high-purity, research-grade LL-37 is absolutely essential if you want data you can trust.
Lower-purity batches are often riddled with contaminants or bits of incorrectly formed peptides. These impurities can throw off your entire experiment, leading to confusing results or, worse, completely invalid conclusions. For any serious scientific work, you need to be using a product with a Certificate of Analysis (CoA) that guarantees purity >99%.
For researchers sourcing high-purity compounds for laboratory studies, Bullit Peptides provides third-party tested LL-37 and other research peptides. You can explore their catalog and view CoA verification on their website.
